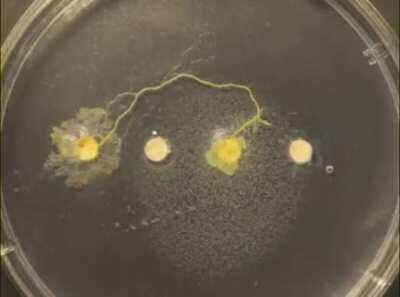
Slime Mold searching for food

gifs
gifs
Browse Other Categories
- amateursatellites
- BadBusinessROBLOX
- CelebritiesBunsButt
- Chinesium
- discordandmemes
- dukecage
- fnki
- gravityshade_1
- irl_petite
- judo
- math
- Mcat
- McKenzie_Mitchell
- MichaelTheMovie
- onexindia
- OnlyIsabellaRamirez
- pyro
- spamtin
- TheMaskedMan1
- TSSHAYBARBIEXX
- u_BolywoodBling
- u_Comprehensive-Law272
- u_monerisia
- u_ty56bo
- Yanderes